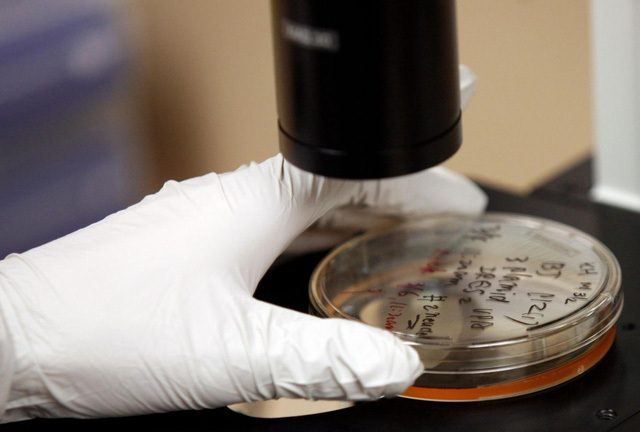
Công bố khoa học mới: Tiêm tế bào gốc để chữa rối loạn cương dương

Công bố khoa học mới: Tiêm tế bào gốc để chữa rối loạn cương dương
Một bước đột phá trong nghiên cứu tế bào gốc đã giúp những nam giới bị rối loạn cương sau phẫu thuật tuyến tiền liệt có cơ hội được có lại một đời sống tình dục bình thường.
Một bước đột phá trong nghiên cứu tế bào gốc đã giúp những nam giới bị rối loạn cương sau phẫu thuật tuyến tiền liệt có cơ hội được có lại một đời sống tình dục bình thường.

'Trên bảo dưới không nghe' là một trong những dấu hiệu của tình trạng suy giảm chức năng tình dục ở nam giới, biểu hiện rõ nhất ở đàn ông độ tuổi 60.